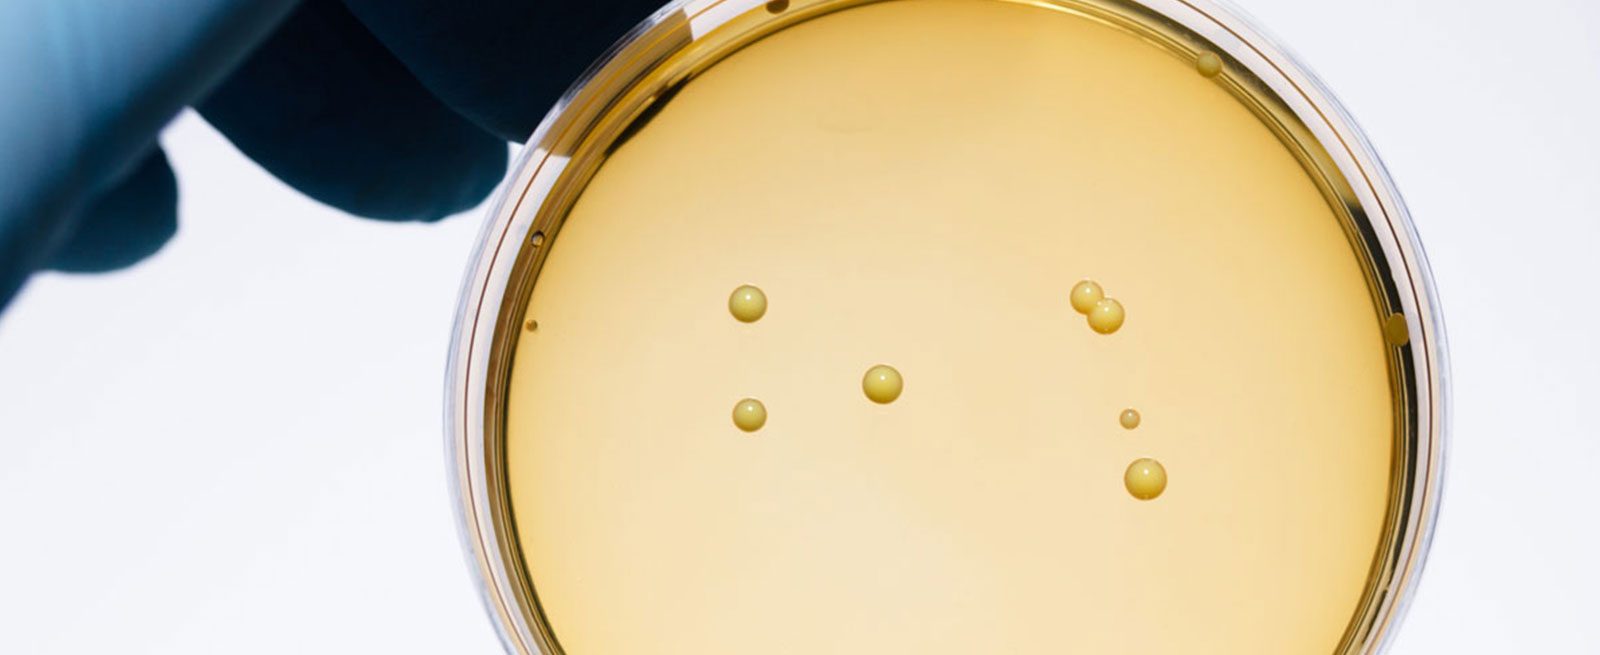

SAP Anbindung und Validierung
Wie Chr. Hansen die Etikettierung modernisiert hat, um alle Prozesse sowie die SAP-Integration mit Hilfe eines validierten NiceLabel Systems zu rationalisieren.
Hintergrund
Chr. Hansen ist ein global tätiges Unternehmen aus dem Bereich Biowissenschaft, das natürliche Lösungen für die Lebensmittel-, Ernährungs-, Pharma- und Agrarindustrie entwickelt. Chr. Hansen entwickeln und produzieren Kulturen, Enzyme, Probiotika und natürliche Farben für eine Vielzahl von Lebensmitteln, Süßwaren, Getränken, Nahrungsergänzungsmitteln und sogar Tierfutter. Chr. Hansen verfügt über eine der weltweit größten kommerziellen Sammlungen von über 30.000 Bakterienstämmen. Gegründet im Jahr 1874, beschäftigt Chr. Hansen über 3.000 Mitarbeiter in mehr als 30 Ländern.
Kennzeichnung von geschäftskritischen Funktionen
Die Kennzeichnung ist ein voll integrierter Bestandteil im Produktions- und Lieferprozess und spielt eine zentrale Rolle im Vertriebsprozess. „Es ist wirklich wichtig, dass der Etikettierungsprozess funktioniert“, erklärt Jens Berth, Senior IT Project Manager bei Chr. Hansen. Es werden rund 3.000 Etikettendruckanforderungen pro Tag erzeugt die auf Beutel-, Karton-, Verpackungs- und Versandetiketten gedruckt werden. Chr. Hansen bedruckt Etiketten an 30 verschiedenen Standorten und verfügt über ein engagiertes Team von Etikettendesignern, um Etikettenvorlagen zu erstellen und zu verwalten.
Herausforderung
Das Etikettierungssystem macht die Validierung schwierig
Das bisherige Etikettierungssystem von Hansen hatte seine Grenzen. „Die Kosten für den Betrieb des Systems waren sehr hoch“, sagt Johnny Krogh Sørensen, IT-Systemmanager, Global IT bei Dr. Chr. Hansen. "Es basierte auf einer 15 Jahre alten Technologie. Hansen ist in der Biowissenschaftsbranche tätig. Jede Software, die einen geregelten Prozess berührt, muss gemäß den von der Food and Drug Administration (FDA) festgelegten Kriterien validiert werden. Die Tatsache, dass das System speziell angefertigt wurde, machte eine Validierung jedoch kostspielig. Außerdem konnten nur interne Benutzer auf das System zugreifen, und der Etikettenerstellungsprozess war mühsam und umständlich.
Der größte Kritikpunkt war jedoch, dass Chr. Hansen keinen 24 Stunden IT-Support für das System bereitstellen konnte, welcher für die Produktion aber erforderlich ist. "Es ist von entscheidender Bedeutung, dass die Produktionslinie nicht anhält", berichtet Jens. „Jede Produktionslinie hat jemanden, der dafür verantwortlich ist, zu identifizieren, warum die Linie stoppt, das Problem zu suchen und es zu beheben. Wenn eine Leitung 20 Minuten lang nicht besetzt ist, erhalten Sie einen Anruf vom oberen Management.“
Um diese Probleme anzugehen, hat Chr. Hansen mit der Suche nach einer neuen Etikettierlösung begonnen. „Wir wollten einen echten webbasierten Zugriff, einen reibungslosen und effektiven Vorlagenentwurf und ein zur Validierung bereites Standardsystem“, erklärt Johnny. Das System musste außerdem globalen Support und Service, ein nahtloses Failover-System und einen zuverlässigen, konsistenten Datenfluss bieten.

Lösung
Enge SAP-Integration mit dem ABAP-Paket von NiceLabel
NiceLabel lieferte mit LMS Enterprise eine Etikettenverwaltungslösung, die voll mit dem System von Chr. Hansen verbunden ist. Chr. Hansens Enterprise-Resource-Planning-System SAP, das das SAP-ABAP-Paket von NiceLabel verwendet. Das ABAP-Paket von NiceLabel sorgt für eine schnelle und einfache Implementierung. „Dank des SAP-Plugins funktioniert es sehr gut“, berichtet Jens.
Chr. Hansen nutzt den in NiceLabel integrierten Genehmigungsprozess für Etikettenvorlagen mit verzögertem Publishing-Workflow. Etikettenvorlagen werden im NiceLabel-System erstellt und im NiceLabel Document Management System (DMS) genehmigt. Die Lösung sendet Etiketteninformationen an SAP, damit diese die Etikettenvorlagen, -varianten, -versionen und -variablen kennen, die in jedem Druckstapel verwendet werden. Diese Vorlagen verfügen über eine vordefinierte Liste zulässiger Variablen, die in SAP gespeichert sind, und erhalten eine Warnung, wenn eine nicht genehmigte Variable verwendet wird. Mit diesem Workflow ist es möglich auch Druckaufträge für eine bestimmte (vorherige) Version einer Etikettenvorlage oder -variante zu senden. Dies ist hilfreich, wenn sie einen Produktionsauftrag erneut ausführen müssen.
Die Web-Druckanwendung erfüllt die Anforderungen für verzögerten Etikettendruck
Um der bisherigen Arbeitsweise von Chr. Hansen gerecht zu werden, hat NiceLabel einen speziell angepassten Arbeitsablauf konfiguriert. Die Druckanwendung ist wichtig, da Etiketten niemals gleichzeitig mit dem Erstellen eines Arbeitsauftrags / einer Druckanforderung in SAP gedruckt werden. „Wir haben Hunderte von Mitarbeitern, die ständig Prozessaufträge in SAP erstellen“, berichtet Jens. „In der Regel erstellen wir Aufträge eine Woche vor dem eigentlichen Druck. Mit der Web-Druckanwendung können wir den Etikettenjob drucken, der zuvor von SAP erstellt wurde. Das ist der Schlüssel für unsere Arbeitsweise. “
Verfügbarkeit rund um die Uhr aktivieren
Um die Anforderungen an die Systemverfügbarkeit rund um die Uhr zu erfüllen, hat Chr. Hansen in den Werken in Avedøre, Dänemark, lokale NiceLabel-Server installiert. Polheim, Deutschland; und Milwaukee, USA. Diese Server werden mit dem Hauptserver (in Hørsholm, Dänemark) synchronisiert, damit sie weiterhin Etiketten erstellen und drucken können, auch wenn der Hauptserver nicht verfügbar ist.
Nutzen Sie die Variantentechnologie von NiceLabel
Chr. Hansen verwendet NiceLabels Variantentechnologie, die speziell für Life-Science-Unternehmen entwickelt wurde, insbesondere für den Pharmateil (Gesundheit und Ernährung) der Produktion. Eine Etikettenvariante ist das fertige Etikett für eine bestimmte SKU. Diese Funktionalität ermöglicht Chr. Hansens QA-Mitarbeiter die Etikettenvarianten vor dem Druck zu genehmigen. Etikettenvarianten verhindern auch unbefugte Änderungen am Etiketteninhalt, nachdem die Variante erstellt wurde. Der Druckbetreiber kann nur einen sehr begrenzten Satz variabler Felder ändern oder eingeben, z. B. die Chargennummer und das Produktionsdatum.
Vorteile
Durch die Implementierung des NiceLabel-Etikettenverwaltungssystems mit seinen universellen Etikettenvorlagen und der Technologie für Etikettenvarianten konnte Chr. Hansen die Anzahl der Etiketten-Vorlagen verkleinern und konsolidieren. „Wir haben mit NiceLabel im Gegensatz zum alten System eine umfassende Bereinigung durchgeführt. Wir konnten die Anzahl der verwendeten Vorlagen wirklich reduzieren “, sagt Jens.
Eine verbesserte Benutzererfahrung kommt Geschäftsbenutzern zugute
Das neue System bietet auch Vorteile für Alle, die mit Etikettendesign arbeiten. „Die Anwender sind sehr zufrieden mit dem Label Designer“, erzählt Jens. „Sie mögen die integrierten Funktionen. Es ist eine viel bessere Benutzererfahrung als die vorherige Lösung. “Johnny stimmt zu: „Der Überblick der Support-Seite ist besser. Es ist ein effektiverer Prozess und ich kann früher als bisher erkennen, ob ein Fehler vorliegt. "
Erfolgreiche Validierung ein wichtiger Meilenstein
Mit dem erfolgreichen Abschluss der Validierung des NiceLabel Label Management Systems hat Hansen Anfang 2019 einen wichtigen Meilenstein erreicht. Sie sind noch dabei, das System auf die gesamte Organisation auszuweiten, aber die Hoffnung ist, dass bis Ende 2019 alle Standorte auf NiceLabel laufen.

Sie sind auf der Suche nach einer Etikettensoftware die auf Ihre Anwendung zugeschnitten ist?
Ich berate Sie umfassend und helfe Ihnen bei der Auswahl.
Rufen Sie mich gerne an.